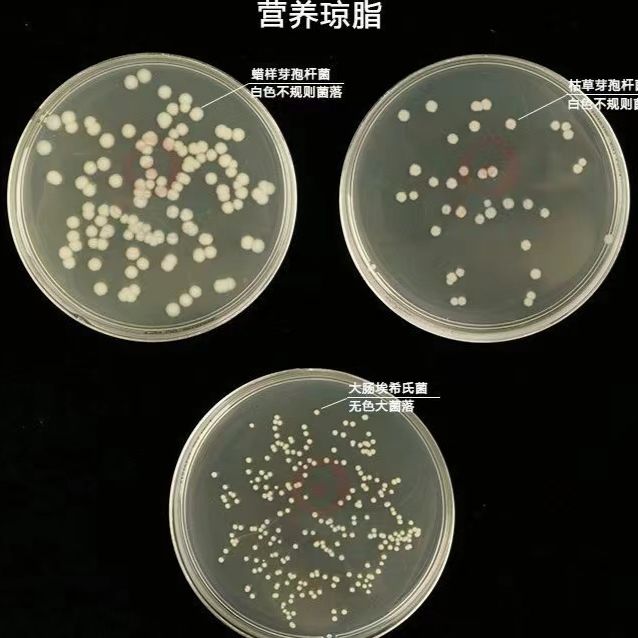
产品封面图

相关产品推荐更多 >
万千商家帮你免费找货
0 人在求购买到急需产品
- 详细信息
- 文献和实验
- 技术资料
- 库存:
72
- 英文名:
Streptomyces nigrificans (Wollenweber emend. Yan et Zhang) Yan et al.
- 保质期:
3年
- 供应商:
优利科(上海)生命科学有限公司
- 保存条件:
2-8℃
- 规格:
冻干粉
| 中文名称:黑化链霉菌 |
| 拉丁名称:Streptomyces nigrificans (Wollenweber emend. Yan et Zhang) Yan et al. |
| 原产国:中国 |
| 模式菌株: 否 |
| 生物安全级别: 一级 |
| 其它保藏中心编号:CGMCC4.163 |
| 培养温度:28℃ |
| 培养时间:3-5d |
| 需氧类型:好氧 |
| 分离基物: |
| 采集地: |
| 保存方法: 冷冻干燥管保藏 |

黑化链霉菌菌种冻存方法:
菌种保藏是指保持微生物菌株的活力和遗传性状的技术。微生物在使用和传代过程中容易发生污染、变异甚至死亡,因而常常造成菌种的衰退。菌种保藏的目的就是使菌株存活、不丢失、不污染杂菌、不发生或少发生变异,保持菌种原有的活性和各种特征。菌种保藏的基本原理是使微生物的生命活动处于半永久性的休眠状态,也就是将微生物的新陈代谢作用限制在最低范围内。

需氧培养:
大多数的细菌、霉菌、放线菌培养法均为需氧培养。
培养基接种微生物后放于35 ℃~37 ℃或25℃恒温培养箱(或水浴箱)中,培养18 h-24h或3d-5d,大多数菌能看到明显的菌落,可以进行计数及鉴定。需氧培养法按培养基的状态来分,可分为三类。
固体培养法是指将微生物接种在固体培养基上生长繁殖的方法,固体培养基包括琼脂平板和琼脂斜面。琼脂平板用于菌落计数和分离菌落和菌落形态观察,琼脂斜面用于保藏。
液体培养法是利用液体培养基对微生物进行培养的方法,用于菌种的选育及生化试验和发酵试验等。
利用半固体培养基进行培养的方法,半固体培养基含有一定的琼脂(0.02%-0.3% ),使培养基有一定的黏度,但没有完全固化。培养时,盛半固体培养基的试管放置于试管架上,然后置于培养箱中进行培养。一般用于生化试验,可用于判别微生物的运动性。
黑化链霉菌注意事项:
1、请务必了解培养微生物需要注意的安全事项,默认由微生物专业技术人员操作;
2、建议严格按照 培养说明来操作,认真阅读说明,尤其是要点提示部分,并记录好菌种编号和菌种制作日期(批号);
3、使用前,认真阅读并理解随货的“菌种培养说明”和“开管说明”如有任何疑问,请于操作前咨询我司。
4、如若有菌种复苏不活或污染等情况,请在收到菌种后1个月内联系我司,逾期将不予受理。


黑化链霉菌相关产品:
| 大肠埃希氏菌 | Escherichia coli | 冻干粉;斜面;菌液;平板 | |
| 苏云金芽孢杆菌天门亚种 | Bacillus thuringiensis subsp. tianmensis | 冻干粉;斜面;菌液;平板 | |
| 苏云金芽孢杆菌苏云金亚种 | Bacillus thuringiensis subsp. thuringiensis | 冻干粉;斜面;菌液;平板 | |
| 苏云金芽孢杆菌猝倒亚种 | Bacillus thuringiensis subsp. sotto | 冻干粉;斜面;菌液;平板 | |
| 稻平脐蠕孢 | Cochliobolus miyabeanus (S. Ito & Kurib.) Drechsler ex Dastur | 斜面;菌液;平板 | |
| 出芽短梗霉 | Aureobasidium pullulans (de Bary) G. Arnaud | 冻干粉;斜面;菌液;平板 | |
| 冬虫夏草 | Ophiocordyceps sinensis (Berk.) G.H. Sung J.M. Sung Hywel-Jones | 斜面;菌液;平板 | |
| 糙皮侧耳(平菇) | Pleurotus ostreatus | 斜面;菌液;平板 | |
| 芽孢杆菌属 | Bacillus sp. | 冻干粉;斜面;菌液;平板 | |
| 奥氏蜜环菌 | Armillaria ostoyae (Romagn.) Herink | 斜面;平板 | |
| 布氏白僵菌(卵孢白僵菌) | Beauveria brongniartii (Sacc.) Petch | 冻干粉;斜面;菌液;平板 | |
| 球孢白僵菌 | Beauveria bassiana (Bals.-Criv.) Vuill. | 冻干粉;斜面;菌液;平板 | |
| 桦褐孔菌 | Inonotus obliquus (Ach. ex Pers.) Pilát | 斜面;菌液;平板 | |
| 青霉菌 | Penicillium expansum Link | 冻干粉;斜面;菌液;平板 | |
| 白囊耙齿菌 | Irpex lacteus (Fr.) Fr. | 斜面;菌液;平板 | |
| 尖镰孢西瓜专化型 | Fusarium oxysporum f.sp. niveum W.C. Snyder & H.N. Hansen | 斜面;菌液;平板 | |
| 球孢白僵菌 | Beauveria bassiana (Bals.-Criv.) Vuill. | 冻干粉;斜面;菌液;平板 | |
| 果生链核盘菌 | Monilinia fructigena Honey | 斜面;菌液;平板 | |
| 蝉花1-13 | Isaria cicadae Miq. | 斜面;菌液;平板 | |
| 镰刀菌属 | Fusarium sp. | 斜面;菌液;平板 | |
| 葡萄芽假丝酵母 | Candida lusitaniae van | 冻干粉;斜面;菌液;平板 |
风险提示:丁香通仅作为第三方平台,为商家信息发布提供平台空间。用户咨询产品时请注意保护个人信息及财产安全,合理判断,谨慎选购商品,商家和用户对交易行为负责。对于医疗器械类产品,请先查证核实企业经营资质和医疗器械产品注册证情况。
 文献和实验
文献和实验随机选择一只豚鼠制作,取棕色皮肤部位去除被毛,经 UV 紫外线照射,波长为 310nm,持续 7 天,未照射部位以斑试器覆盖,建立皮肤黑化模型,运用皮肤生物物理学检测和组织学染色分析技术可以用于美白化妆品原料的功效评价和机制研究。
自十九世纪后半期以来,随着欧洲工业城市的发展,栖息于其附近的蛾类的深暗色变异增加了,这种现象特称之为工业黑化。最初引人注意的是英国,嗣后欧洲各地均可见到。根据 E. B. Food( 1965)等的研究,产生这种现象的原因,是在田园地带原来的淡色类型的蛾类,不易被人们发现,也不易被小鸟捕食,以致残存下来;但是在工业地带,由于产生煤烟,致使周围环境呈现黑色,所以不难推测,暗色类型被小鸟发现的机会更少。根据 A。 B。 P。 Kettlewell( 1957)的看法,呈现这种突然
放线菌属于原核生物系统进化树上的(G+C)摩尔百分含量(mol%)高的革兰氏阳性菌(Eubacteria)分枝类群,它虽然具有原核生物特有的分子生物学特性,但在其不同类群中,细胞壁的化学组分变化很大。在做大肠杆菌超声时,采用的是400W,破碎5s停5s的方法,效果不错,但是用在链霉菌上,由于细胞壁组成差异一般没什么效果。 链霉菌(放线菌)超声破碎前处理